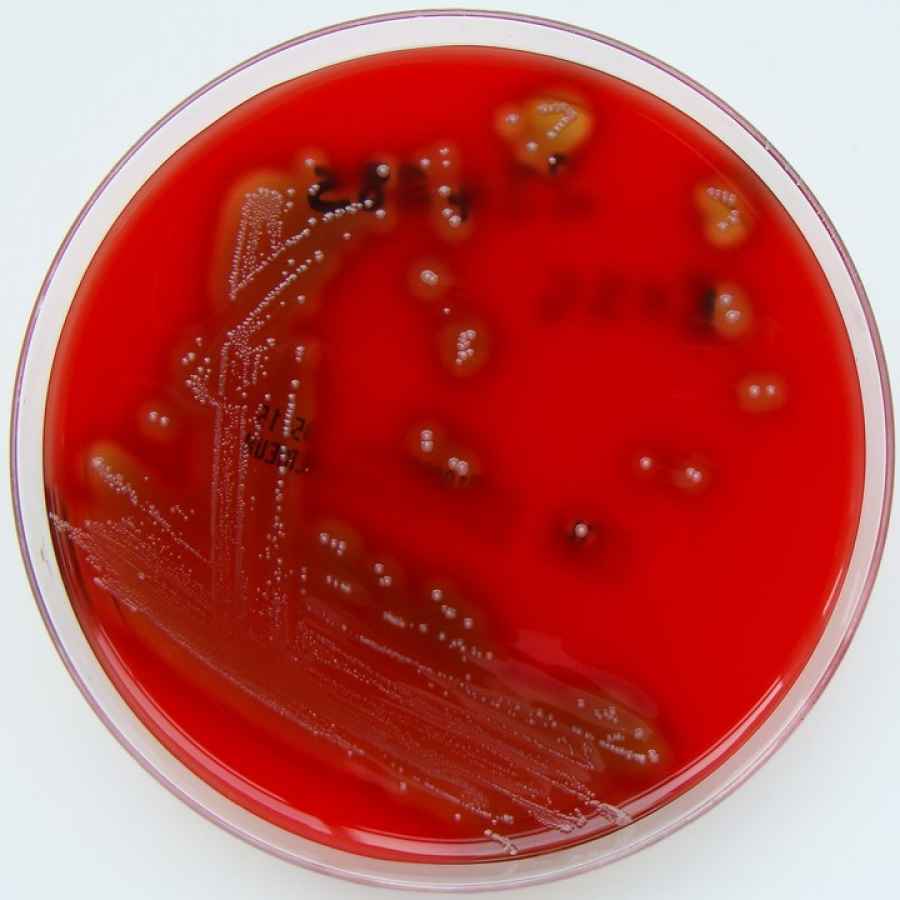
Streptococcus pyogenes. Una imagen de la bacteria que afect&oacute; a cinco chicos

Mostrando artículos por etiqueta: alerta
OPS instó a estar alertas ante nuevos casos de coronavirus en las Américas
La Directora de la Organización Panamericana de la Salud (OPS), Carissa Etienne, instó hoy a los países de la región de las Américas a estar preparados para detectar tempranamente, aislar y cuidar a pacientes infectados con el nuevo coronavirus, ante la posibilidad de recibir viajeros provenientes de países donde hay transmisión del virus.
“Los servicios de salud tienen que estar preparados porque muy probablemente serán ellos el punto de entrada donde se detectarán casos del nuevo coronavirus, como ya ha sucedido con epidemias anteriores”, afirmó Etienne. “La OPS está lista para apoyarlos porque detectar tempranamente los casos puede prevenir la propagación de la enfermedad”, sostuvo durante una sesión informativa para los embajadores ante la Organización de los Estados Americanos en Washington.
Según el reporte de situación de la OMS emitido el 24 de enero, en el mundo se notificaron 846 casos confirmados de infección por 2019-nCoV, 830 en China. De ellos, 177 casos fueron severos y 25 fallecieron. De los casos confirmados, el 80% eran personas mayores de 40 años y el 64%, hombres.
Otros casos se reportaron en Tailandia (4), Japón (2); Hong Kong (2), la República de Corea (2), Macao (2) y Singapur (1). En las Américas, los Estados Unidos confirmaron 2 casos de viajeros provenientes de China, y otros países descartaron o están investigando posibles casos.
En Wuhan, China, los trabajadores de salud fueron uno de los grupos afectados, algo que ha puesto bajo presión a los servicios de salud. Por esta razón, Etienne subrayó la importancia de informar y entrenar al personal de salud de la región y promover entre ellos el uso del equipo de prevención de infecciones para protegerlos de cualquier enfermedad.
La Directora de la OPS mencionó que la organización ha activado su sistema de manejo de incidentes, y que desde inicios de enero ha compartido información con los ministerios de Salud a través de los canales del Reglamento Sanitario Internacional, y a través de sus representantes en los países.
También manifestó que continuará actualizando la información sobre lo que los países pueden hacer para responder en forma efectiva a este nuevo virus acerca del que todavía hay mucha incertidumbre.
El 22 y 23 de enero de 2020, el Director General de la OMS, doctor Tedros Adhanom Ghebreyesus, convocó al Comité de Emergencia para asesorarlo sobre si el brote en China constituye una emergencia de salud pública de interés internacional (PHEIC). El Director de la OMS decidió no declarar una emergencia de salud pública en este momento. Sin embargo, afirmó que es una emergencia en China, y que el brote representa un alto riesgo a nivel regional y mundial.
“El hecho de que la OMS no haya declarado una emergencia no significa que no estemos ante un desafío grande en salud pública”, consideró el Subdirector de la OPS, doctor Jarbas Barbosa. “Con la globalización y los viajes internacionales no es inesperado que los países de la región puedan recibir personas con el virus”, dijo, pero aclaró que “tener un caso importando no es lo mismo que tener transmisión local o sostenida en un país”.
El Director del Departamento de Emergencias de la OPS, doctor Ciro Ugarte, destacó que la vigilancia epidemiológica para la detección temprana de casos, así como el manejo de pacientes con el equipo de protección adecuado pueden limitar la transmisión de persona a persona, reducir la posibilidad de que se produzcan casos secundarios y evitar una propagación de la enfermedad.
“La naturaleza del 2019-nCoV es muy similar a la gripe, y los síntomas son similares a los del SARS (síndrome respiratorio agudo grave): fiebre, tos, dificultad para respirar y neumonía”, indicó Ugarte. Agregó que aún se desconoce el tratamiento para el nuevo coronavirus y que no hay disponible una vacuna.
Fuente: Consenso salud
Alerta epidemiológica: 61 casos de sarampión
Nuevos casos de sarampión en Argentina. Circulación en el Área Metropolitana de Buenos Aires Ante la detección de nuevos casos de sarampión y su aparición en municipios donde hasta el momento no se habían detectado y con el fin de lograr la interrupción de la transmisión viral, la Secretaría de Gobierno de Salud de la Nación insta a la población a verificar su estado de vacunación. Se refuerza la necesidad de aplicar la dosis “cero” a niños de 6 a 11 meses, residentes en la Ciudad Autónoma de Buenos Aires y de las regiones Sanitarias V, VI, VII y XII de la Provincia de Buenos Aires. Además, todos los niños y niñas entre 13 meses a 4 años, inclusive, de las mismas jurisdicciones deberán acreditar la aplicación de al menos 2 dosis de vacuna triple viral después del primer año de vida. Se pone énfasis, además, en que el personal de salud debe acreditar 2 dosis de vacuna con componente antisarampionoso (aplicadas después del primer año de vida) o bien contar con certificación de IgG positiva para sarampión.
SITUACION ACTUAL
Evolución del brote en curso iniciado en la Semana Epidemiológica 36. Argentina 2019 Desde comienzos de septiembre (Semana Epidemiológica –SE- 36) Argentina está atravesando el mayor brote de sarampión desde la eliminación de la circulación endémica del virus, alcanzada en el año 2000 y certificada en 2016 por la Organización Panamericana de la Salud. Desde el 4 de septiembre, se han contabilizado 54 casos en total (52 detectados en Argentina y 2 en España). El genotipo detectado en todos los casos es el D8, linaje Mvs/Gir Somnath.IND/42.16, de amplia circulación en la Región de las Américas. La situación actual da cuenta de la dinámica epidemiológica mundial en relación con esta enfermedad. En la Región de las Américas, 14 de los 35 estados partes confirmaron casos en el presente año y dos países restablecieron la circulación endémica: Brasil y Venezuela. A la SE 45, Brasil presenta el brote más significativo con 11.871 casos confirmados. Según el reporte oficial del país a la semana 43, la cifra de estados afectados es de 19, incluyendo los del sur de ese país (Sao Paulo –reúne el 96% de los casos totales-, Paraná, Santa Catarina y Río Grande do Sul, todos los estados de Nordeste (con excepción de Sergipe) y los de Bahía y Río de Janeiro2. La distribución de los casos en Brasil toma especial relevancia habida cuenta de los constantes desplazamientos con motivos comerciales, turísticos y por la proximidad del receso estival. En tanto, en la Argentina, la Secretaría de Gobierno de Salud confirmó 6 nuevos casos de sarampión, desde los comunicados en el Boletín Integrado de Vigilancia publicado el pasado 15 de noviembre. Los casos registrados desde la SE 36 ocurrieron en la Ciudad Autónoma de Buenos Aires (14) y en la Provincia de Buenos Aires (38) en los siguientes partidos: Hurlingham (1), Ituzaingó (6), Lanús (1), La Matanza (6), Lomas de Zamora (3), Merlo (5), Moreno (12), Quilmes (1), Tigre (1) y Vicente López (2). La fecha de exantema del último caso de CABA fue 4 de octubre y del de Provincia de Buenos Aires 11 de noviembre. Entre la SE 36 y 47, el total de los casos confirmados presenta mayor concentración en menores de 1 año. En el siguiente grafico se detalla la distribución de casos por edad y tasas de incidencia.
La confirmación de casos en personas mayores de 20 años de edad revela la necesidad de continuar con los esfuerzos para poder alcanzar rápidamente con las acciones de vacunación a la población de adultos de nacidos a partir del año 1965. Asimismo, se insta al equipo de salud a mantener alta la sospecha de la enfermedad en este grupo etario, teniendo en cuenta que, además de los menores de 5 años, son los adultos mayores de 30 años los que tienen la mayor probabilidad de sufrir complicaciones y fallecer.
Indicaciones de vacunación vigentes
De acuerdo a la situación epidemiológica, se evaluará la necesidad de ampliar la zona geográfica para la vacunación de los menores de un año.
Para el equipo de salud de todo el país
Todas las personas que trabajan en el nivel asistencial (por ejemplo, mesa de entradas, limpieza, seguridad, laboratorio, planta médica y de enfermería, etc.) deben acreditar la aplicación de dos dosis de vacuna con componente contra el sarampión, después del año de vida (monovalente, doble o triple viral). Alternativamente, podrá establecerse la inmunidad con serología IgG positiva para sarampión.
Para población de todo el país Verificar y completar esquema de vacunación de acuerdo a la edad:
De 12 meses a 4 años inclusive: deben acreditar UNA DOSIS de vacuna triple viral (sarampión-rubéolapaperas).
Mayores de 5 años, adolescentes y adultos: deben acreditar DOS DOSIS de vacuna con componente contra el sarampión aplicada después del año de vida (monovalente, doble o triple viral) o contar con serología IgG positiva para sarampión.
Las personas nacidas antes de 1965 son consideradas inmunes y no deben vacunarse.
Acciones Intensivas de vacunación para:
1- Ciudad Autónoma de Buenos Aires (CABA) y 2- Las siguientes regiones de la provincia de Buenos Aires: •Región V: Campana, Escobar, Exaltación de la Cruz, General San Martín, José C. Paz, Malvinas Argentinas, Pilar, San Fernando, San Isidro, San Miguel, Tigre, Vicente López y Zárate; •Región VI: Avellaneda, Lanús, Lomas de Zamora, Almirante Brown, Berazategui, Esteban Echeverría, Ezeiza, Florencio Varela y Quilmes; •Región VII: Gral. La Heras, Gral. Rodríguez, Luján, Marcos Paz, Merlo, Hurlingham, Ituzaingó, Morón, Tres de Febrero y Moreno. •Región XII: La Matanza. Los niños y las niñas entre 6 y 11 meses de vida, DEBEN recibir la denominada “dosis cero” de vacuna triple viral, que no es válida como esquema de vacunación de calendario. Los niños y las niñas de 13 meses a 4 años inclusive DEBEN acreditar 2 dosis de vacuna triple viral después del año de vida.
Para residentes en Argentina que viajen al exterior
Niños menores de 6 meses de vida: se indica aplazar y/o reprogramar el viaje, puesto que en ellos la vacuna triple viral está contraindicada y es el grupo etario de mayor vulnerabilidad.
Niños de 6 a 11 meses de vida: en caso de no poder aplazar el viaje, deben recibir una dosis de vacuna triple viral (“dosis cero”). Esta dosis no debe ser tenida en cuenta como esquema de vacunación de calendario. Se recomienda no viajar al exterior.
Niños de 13 meses a 4 años inclusive: deben acreditar al menos 2 dosis de vacuna triple viral. La primera dosis correspondiente al año de vida y la dosis de Campaña Nacional de Seguimiento 2018. Aquellos niños que no hayan recibido la dosis de Campaña 2018, deberán recibir una dosis adicional.
Mayores de 5 años, adolescentes y adultos: deben acreditar dos dosis de vacuna con componente contra el sarampión (monovalente, doble o triple viral) aplicada después del año de vida o confirmar a través de un estudio de laboratorio la presencia de anticuerpos contra sarampión (serología IgG+ contra sarampión). De no contar con las dos dosis recomendadas, la vacuna debe ser aplicada como mínimo 15 días antes del viaje.
Embarazadas: pueden viajar si acreditan dos dosis de vacuna con componente antisarampionoso (monovalente, doble o triple viral) aplicada después del año de vida o confirmar a través de un estudio de laboratorio la presencia de anticuerpos contra sarampión (serología IgG+ contra sarampión). Se desaconseja viajar a las embarazadas sin antecedentes comprobables de vacunación o sin anticuerpos contra el sarampión. Además, tener en cuenta otras enfermedades virales que pueden comprometer su salud (especialmente zika). Vigilancia Epidemiológica Caso sospechoso: Paciente con fiebre (temperatura axilar mayor a 38ºC) y exantema, o cualquier caso en que el profesional de la salud sospeche sarampión o rubéola.
Modalidad de la vigilancia: Notificación inmediata nominal: Todo caso sospechoso deberá notificarse al Sistema Nacional de Vigilancia de la Salud a través del SNVS2.0, dentro de las 24 horas de detectado, con adelanto por vía telefónica a la autoridad local responsable de las primeras acciones de bloqueo Actividades ante un caso sospechoso
Informar inmediata y fehacientemente a la autoridad sanitaria por el medio disponible SIN esperar resultados de laboratorio.
Notificar dentro de las 24 horas al Sistema Nacional de Vigilancia de la Salud (SNVS2.0) por parte del personal que asista al paciente y del laboratorio que obtenga, reciba o procese muestras ante la identificación del caso sospechoso.
Confeccionar de manera completa la ficha de investigación epidemiológica y reportar los datos de la misma en la ficha de notificación originalmente registrada en el SNVS2.0
Recolectar muestras para el diagnóstico etiológico: Tomar siempre muestra de sangre; además, tomar muestra para detección viral: orina hasta 14 días posteriores a la aparición de exantema e hisopado nasofaríngeo (HNF) hasta 7 días posteriores. Todas las muestras deben ser estudiadas en forma simultánea para sarampión y rubéola.
Aislamiento del paciente: Disponer el aislamiento del paciente hasta los 7 días siguientes del inicio del exantema para evitar contagios. Evitar la circulación en transportes públicos y dentro de las instituciones. En caso de internación se debe proceder al aislamiento respiratorio.
Fuente: Cofa
Llaman a aplicarse la vacuna del sarampión
A partir de los brotes de sarampión presentes en la región y el intercambio permanente turístico, comercial y laboral, la Secretaría de Gobierno de Salud llama a la población a acercarse a un centro de salud u hospital para recibir la vacuna en caso de no habérsela aplicado con anterioridad.
Tal como indica el Calendario Nacional de Vacunación, los niños de 12 meses a 5 años deben acreditar una dosis de vacuna triple viral (que protege contra el sarampión, la rubéola y las paperas) mientras que los mayores de 5 años tienen que contar con dos dosis de vacuna doble o triple viral. Las personas nacidas antes de 1965 no necesitan vacunarse porque se consideran protegidos por haber estado en contacto con el virus.
La circulación del virus del sarampión en la Región de las Américas continúa activa. Durante el año se notificaron más de 4.500 casos confirmados, los cuales se concentraron en su mayoría en Estados Unidos y Brasil. Además, cabe destacar que según el Boletín Epidemiológico del Ministerio de Salud de Brasil, en el período que abarca desde el 09 de junio al 31 de agosto fueron confirmados por laboratorio un total de 2.753 casos, de estos el 98.3% se concentran en dos municipios del estado de San Pablo, en especial en la región metropolitana.
Dada la situación epidemiológica mundial y el masivo tránsito de viajeros desde y hacia países con circulación viral, existe alto riesgo de importación de casos y desarrollo de brotes si una persona enferma o que esté incubando la enfermedad ingresa al país. Para evitarlo, es fundamental que toda la población esté correctamente vacunada.
En Argentina la enfermedad se encuentra eliminada desde el año 2000 pero para mantener esa situación son necesarias coberturas de vacunación altas. La vacuna es muy segura
El sarampión es una enfermedad viral muy contagiosa que puede tener curso grave o fatal y causar secuelas permanentes. Se propaga fácilmente cuando la persona infectada elimina secreciones respiratorias al hablar, toser o estornudar, o por estar en contacto con cualquier objeto contaminado. Una persona al excretar el virus a través de la saliva puede infectar hasta 14 personas. Los síntomas se caracterizan por fiebre alta, secreción nasal, conjuntivitis, tos, erupción en la cara y cuello que se va extendiendo al resto del cuerpo, y la aparición de pequeñas manchas blancas en la cara interna de la mejilla.
Dada la situación regional que la Secretaría de Gobierno de Salud viene observando, el país cuenta con las vacunas necesarias para proteger a la comunidad y poder así mantener la eliminación de la circulación endémica del sarampión. Además, con el fin de fortalecer la capacidad de los equipos de salud de todas las jurisdicciones para responder de manera rápida, eficiente y oportuna ante casos importados de sarampión, la Secretaría organizó junto con la Organización Panamericana de la Salud, un taller nacional en el que participan referentes provinciales que se está desarrollando en la Ciudad de Buenos Aires desde el martes hasta el viernes.
Por otra parte, el año pasado la Secretaría de Gobierno de Salud realizó una a campaña nacional de seguimiento de sarampión y rubéola a través de la aplicación de una dosis adicional de la vacuna a los niños de 13 meses a 4 años de todo el país. La misma alcanzó una cobertura del 89 por ciento.
En el siguiente vínculo, actualización epidemiológica sobre la confirmación de dos casos de sarampión en turistas extranjeros: https://www.argentina.gob.ar/sites/default/files/sarampion_alerta-11-09-2019.pdf
Alerta por una bacteria: cuáles son los síntomas para consultar al médico
La muerte de dos chicos infectados con la bacteria Streptococcus pyogene encendió la alarma. La Secretaría de Salud emitió un alerta epidemiológica, y hay otros tres pacientes internados. Todos los afectados tenían entre 5 meses y 7 años.
No hay vacuna que prevenga la enfermedad, pero desde Salud intentaron llevar tranquilidad y aseguraron que no hay un brote. Pero, sí, pidieron que los padres hagan una consulta precoz para evitar complicaciones.
“Es una enfermedad muy vieja que provoca faringitis y lesiones de piel como escarlatina. En este caso, estos pacientes hicieron una forma que pasó la bacteria a la sangre e hicieron cuadros muy graves. La forma más grave tiene una mortalidad del 20% al 30%. No se trató ni se consultó a tiempo al médico. Estos casos, tratados con la penicilina, se curan la enorme mayoría”, explicó a los medios el infectólogo Eduardo López, jefe del Departamento de Medicina del Hospital Ricardo Gutiérrez.
Según el especialista, el contagio se da mayoritariamente de manera intrafamiliar, pero “tratados con antibióticos, en 24 horas estos pacientes dejan de contagiar. La forma grave es baja de contraer. La forma común es la faringitis, y en la época de primavera el 20% de la faringitis con fiebre son provocadas por esta bacteria”.
López explicó que el alerta oficial tiene la finalidad de que, justamente, los médicos estén alerta y también la población, para consultar de manera temprana. La bacteria afecta a dos órganos, la garganta y la piel: allí se manifiesta y a esas señales hay que prestar atención. “Los síntomas son dos: cuando tienen faringitis, dolor de garganta, fiebre alta y dificultad para tragar, y cuando se brotan en la escarlatina o con lesiones de piel que se rascan o se duelen. Cuando ocurre eso, hay que consultar al médico”.
“Tranquilizamos a la gente diciendo que es muy raro que haya pasado lo que pasó con estos chicos. No es difícil diagnosticar esta enfermedad. Hay que concurrir rápido al hospital”, remarcó.
Fuente: Clarín Salud
Alerta por el regreso de la difteria a las Américas
La OPS lanzó un alerta por casos de difteria en las Américas. Durante este año se notificaron 123 casos en Venezuela, 80 en Haití y un caso en Brasil. La difteria es una enfermedad causada por una toxina producida por la bacteria Corynebacterium diphtheriae. Se propaga fácilmente a través de los estornudos y la tos.
“La difteria puede causar fiebre y dolor de garganta. Evoluciona con compromiso del estado general y una gruesa membrana gris cubre el interior de la garganta. Si no se trata oportunamente la enfermedad puede causar dificultades para tragar o problemas graves como parálisis, insuficiencia cardíaca e infección generalizada”, explicaron desde la OPS.
El uso generalizado de la vacuna contra la difteria permitió que no se detecten casos en la Argentina desde 2006. El Calendario Nacional contempla la vacunación con la pentavalente a los 2, 4 y 6 meses de vida. Continúa el esquema a los 18 meses con la cuádruple, a los 6 años con la triple bacteriana celular, a los 11 con la bacteriana acelular y cada diez años con la doble bacteriana. Todas estas dosis contienen el componente antidiftérico que protege contra la enfermedad.
Lo más visto
- Covishield, la vacuna que India lanzó con Oxford-AstraZeneca
- El gobierno establece los requisitos para la producción de cannabis medicinal
- Anmat aprobó en el país la primera vacuna que protege contra el dengue
- Comunicación de Novo Nordisk: Diferencias en la indicación de Victoza® y Saxenda®
- Ibupirac declarado apto para celíacos